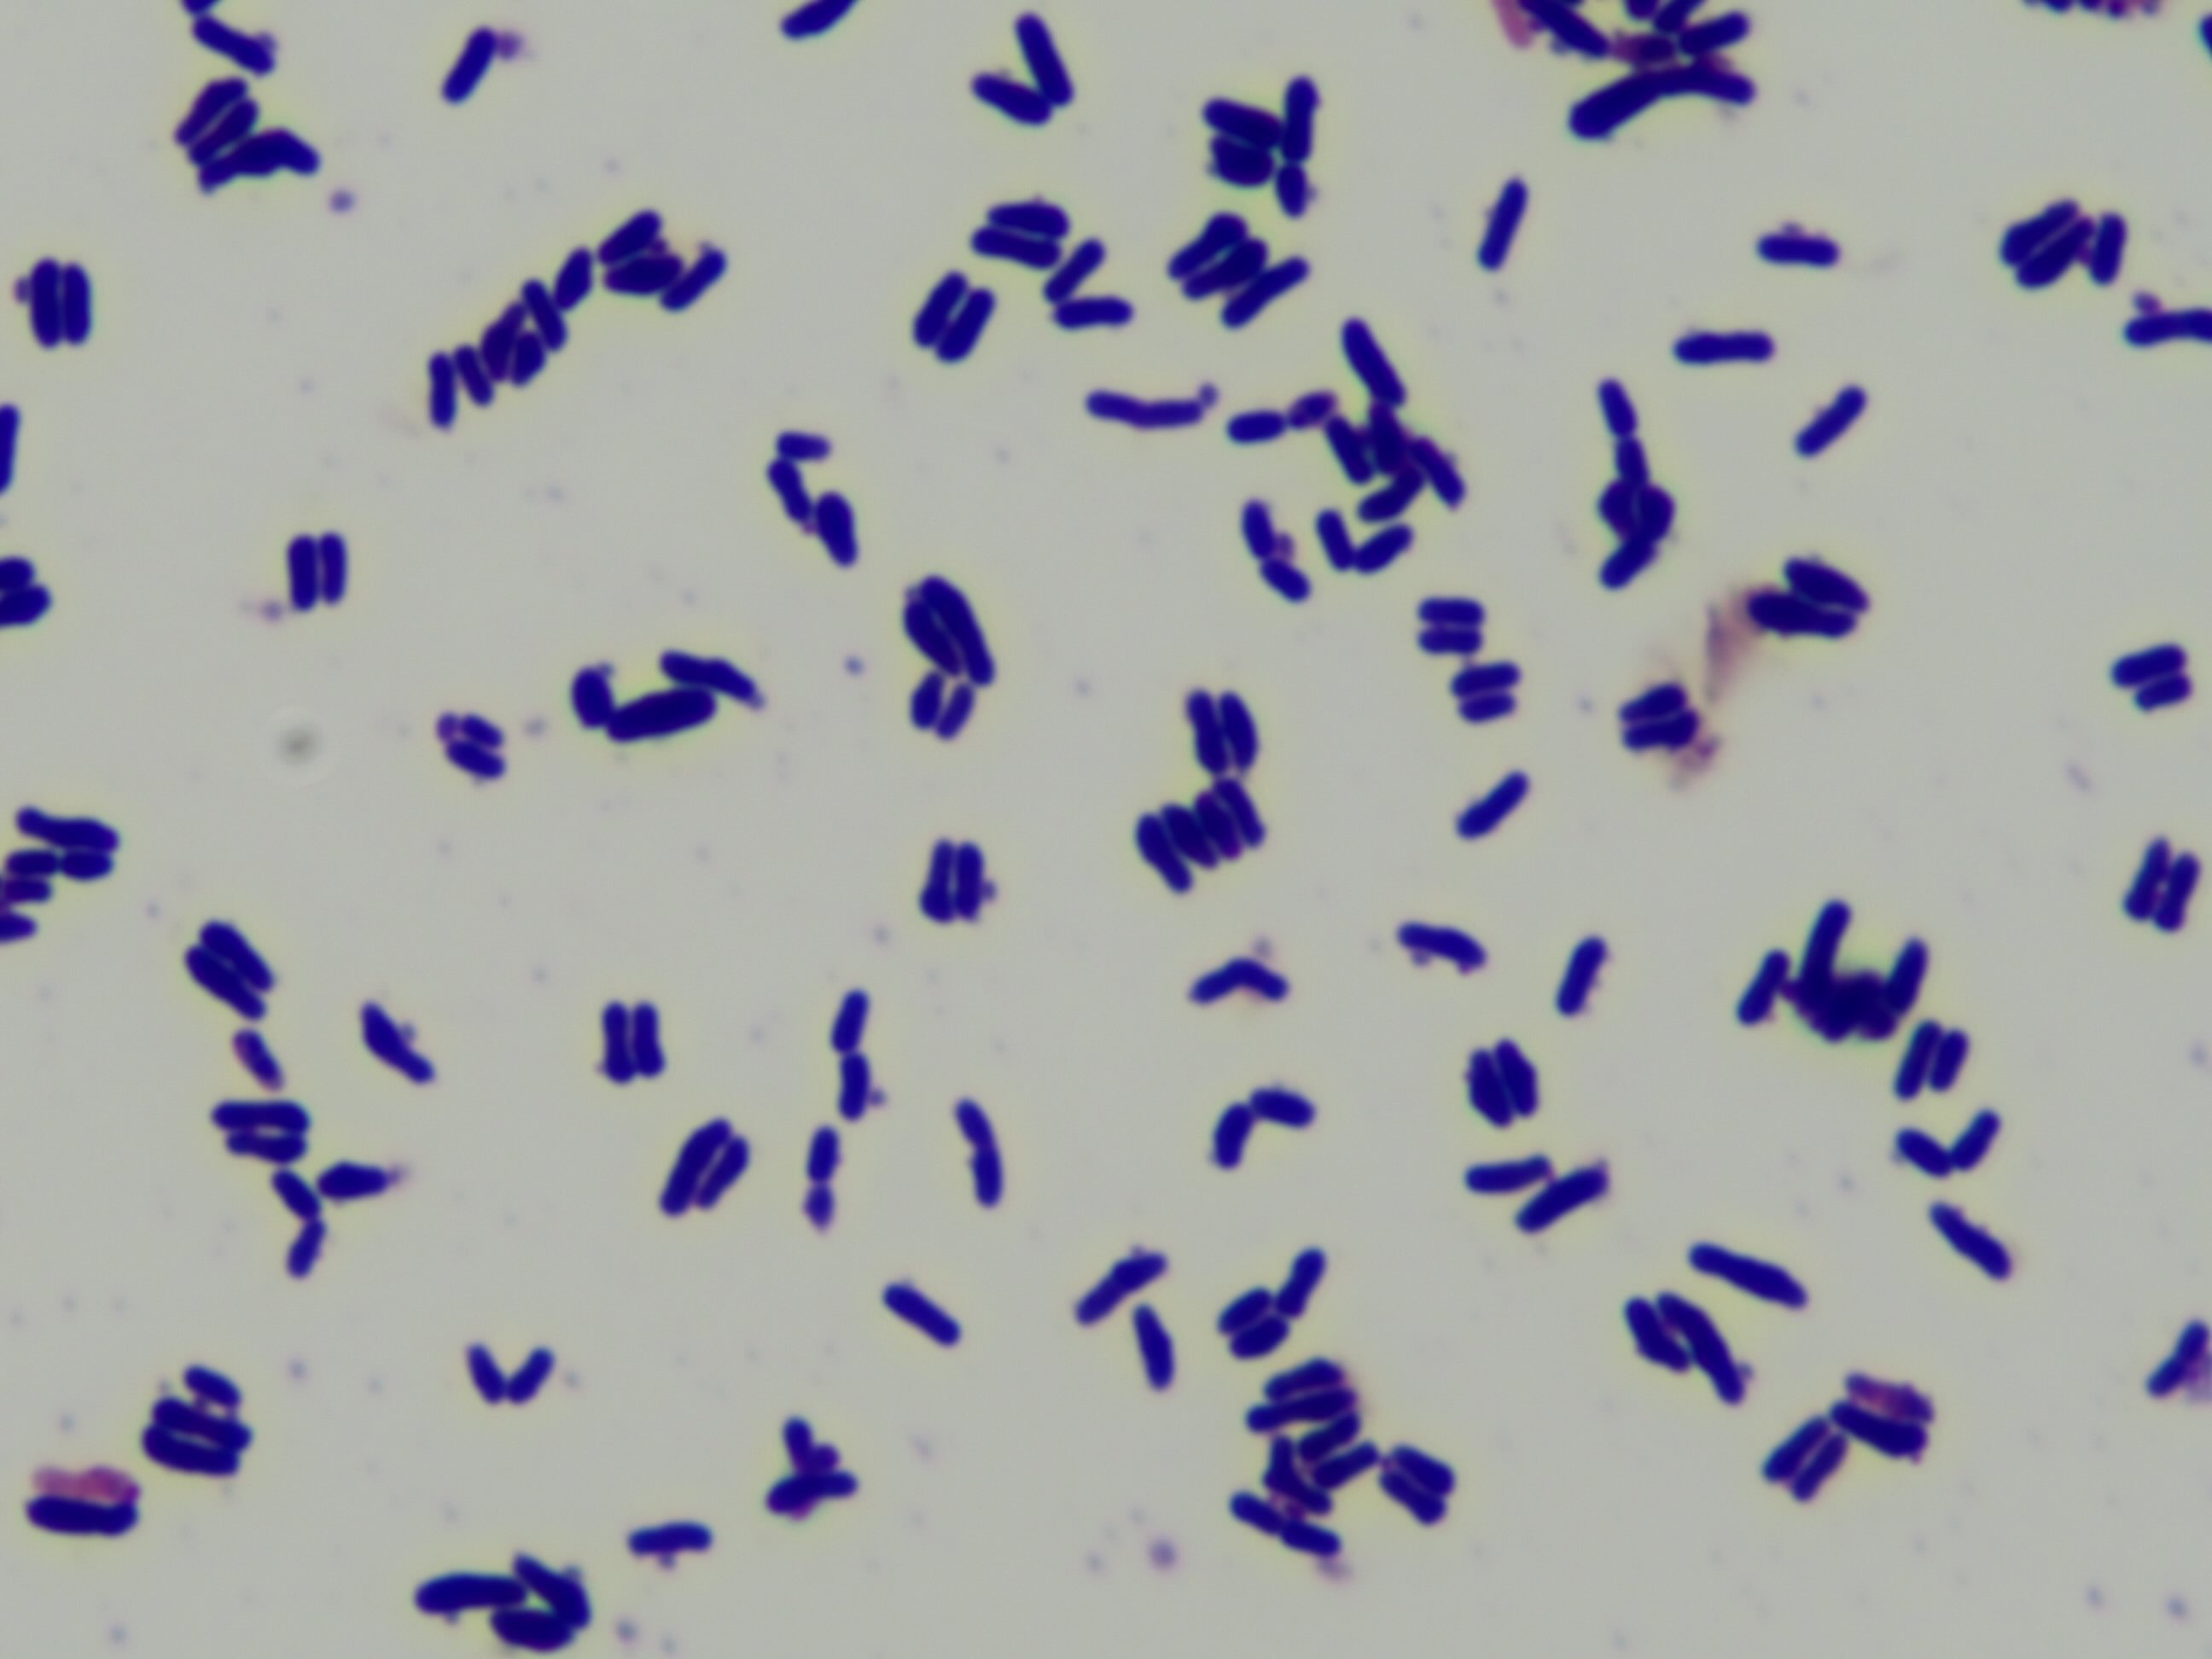

Bifidobacterium animalis subsp. lactis
Product description
Initially classified as Bifidobacterium bifidum, it was reclassified to Bifidobacterium animalis and further categorized into subspecies lactis. This subspecies is rod-shaped, gram-positive, and anaerobic, commonly found in the intestines of mammals, including humans.
Read more
Specifications
| Categories | Fungi & Yeasts, Microorganisms & Probiotics, Mushrooms | Microorganisms & ProbioticsOther Microorganisms & Probiotics; Digestive Health |
|---|---|
| Supplied from | India |
Products from other suppliers
❮
❯
-

Sea Cucumber & Oyster Tablet
-

Bifidobacterium longum BORI
-

Pep2Dia®, new bioactive ingredient that regulates blood sugar levels after meals.
-

CRISPYTEC Series
-

GLP-1 Probiotics - Akkermansia muciniphila AH39 & Lactobacillus casei CCFM419
-

BiPRO® 9500 whey protein isolate (WPI)
-

Crispact® Stick packs
-

Nextida® GC
-

Gasbet tablets
-

NEUROMAX®
Bifidobacterium animalis subsp. lactis